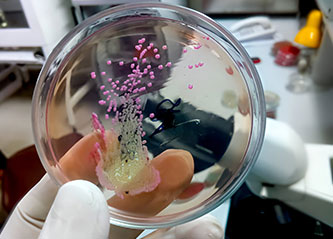

Medsure is well positioned to supply a comprehensive range of products across key medical and scientific divisions. From diagnostic solutions such as microbiology media, rapid tests, and molecular kits, to laboratory essentials including glassware, reagents, and instruments, we ensure accuracy and reliability in every setting. Our portfolio also covers clinical consumables such as gloves, protective wear, and sterile disposables, as well as advanced equipment for imaging, pathology, and life science research. In addition, Medsure supports public health and hospital divisions with critical care items, infection control products, and emergency response supplies. This wide scope allows us to meet the needs of healthcare providers, laboratories, and research institutions with high-quality, trusted solutions.



